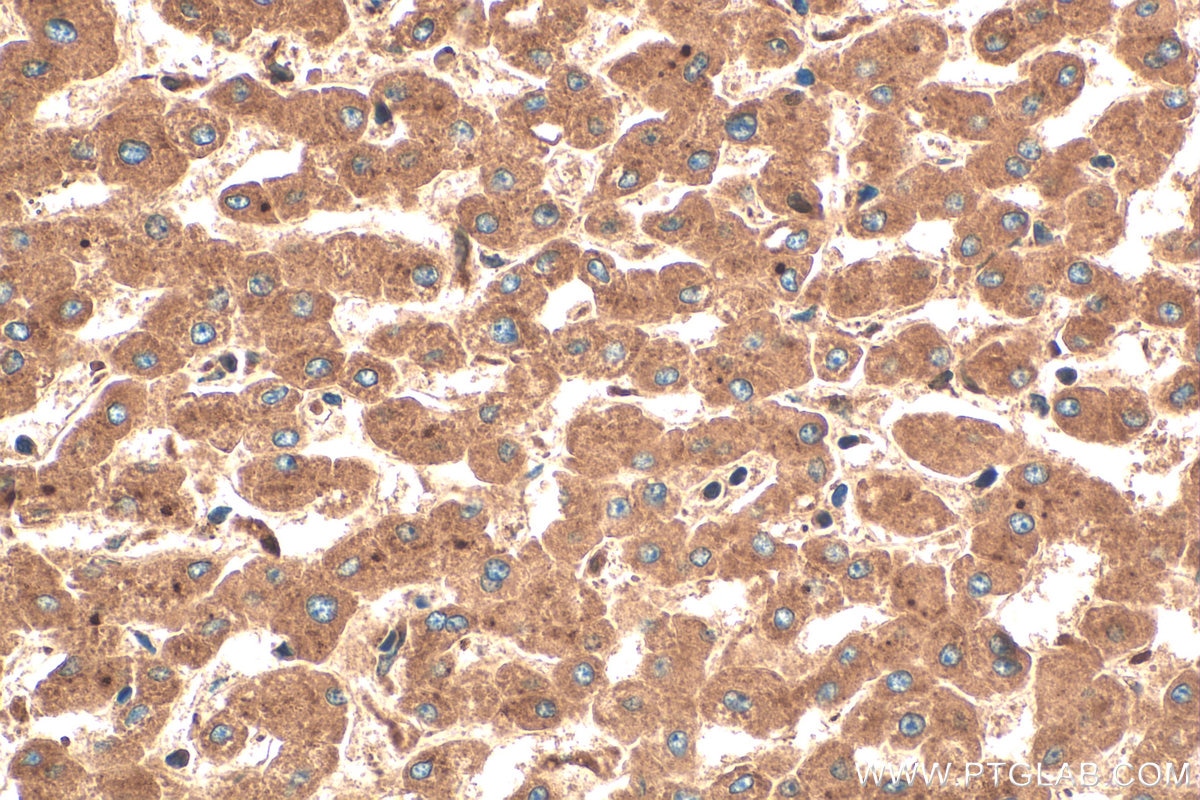
Immunohistochemistry (IHC) staining of human liver tissue using Alpha 1 antichymotrypsin Polyclonal antibody (12192-1-AP)

Validation Data Gallery
Tested Applications
| Positive WB detected in | human blood tissue, COLO 320 cells, human colon tissue |
| Positive IP detected in | COLO 320 cells |
| Positive IHC detected in | human tonsillitis tissue, human liver tissue, human spleen tissue Note: suggested antigen retrieval with TE buffer pH 9.0; (*) Alternatively, antigen retrieval may be performed with citrate buffer pH 6.0 |
| Positive FC (Intra) detected in | HepG2 cells |
Recommended dilution
| Application | Dilution |
|---|---|
| Western Blot (WB) | WB : 1:500-1:1000 |
| Immunoprecipitation (IP) | IP : 0.5-4.0 ug for 1.0-3.0 mg of total protein lysate |
| Immunohistochemistry (IHC) | IHC : 1:50-1:500 |
| Flow Cytometry (FC) (INTRA) | FC (INTRA) : 0.25 ug per 10^6 cells in a 100 µl suspension |
| It is recommended that this reagent should be titrated in each testing system to obtain optimal results. | |
| Sample-dependent, Check data in validation data gallery. | |
Published Applications
| WB | See 8 publications below |
| IHC | See 3 publications below |
| IF | See 1 publications below |
Product Information
12192-1-AP targets Alpha 1 antichymotrypsin in WB, IHC, IF, FC (Intra), IP, ELISA applications and shows reactivity with human samples.
| Tested Reactivity | human |
| Cited Reactivity | human, mouse, rat, monkey |
| Host / Isotype | Rabbit / IgG |
| Class | Polyclonal |
| Type | Antibody |
| Immunogen |
CatNo: Ag2830 Product name: Recombinant human SERPINA3,AACT protein Source: e coli.-derived, PET28a Tag: 6*His Domain: 70-423 aa of BC010530 Sequence: DKNVIFSPLSISTALAFLSLGAHNTTLTEILKGLKFNLTETSEAEIHQSFQHLLRTLNQSSDELQLSMGNAMFVKEQLSLLDRFTEDAKRLYGSEAFATDFQDSAAAKKLINDYVKNGTRGKITDLIKDLDSQTMMVLVNYIFFKAKWEMPFDPQDTHQSRFYLSKKKWVMVPMMSLHHLTIPYFRDEELSCTVVELKYTGNASALFILPDQDKMEEVEAMLLPETLKRWRDSLEFREIGELYLPKFSISRDYNLNDILLQLGIEEAFTSKADLSGITGARNLAVSQVVHKAVLDVFEEGTEASAATAVKITLLSALVETRTIVRFNRPFLMIIVPTDTQNIFFMSKVTNPKQA 相同性解析による交差性が予測される生物種 |
| Full Name | serpin peptidase inhibitor, clade A (alpha-1 antiproteinase, antitrypsin), member 3 |
| Calculated molecular weight | 448 aa, 48 kDa |
| Observed molecular weight | 44-70 kDa |
| GenBank accession number | BC010530 |
| Gene Symbol | Alpha 1 Antichymotrypsin |
| Gene ID (NCBI) | 12 |
| RRID | AB_10344682 |
| Conjugate | Unconjugated |
| Form | |
| Form | Liquid |
| Purification Method | Antigen affinity purification |
| UNIPROT ID | P01011 |
| Storage Buffer | PBS with 0.02% sodium azide and 50% glycerol{{ptg:BufferTemp}}7.3 |
| Storage Conditions | Store at -20°C. Stable for one year after shipment. Aliquoting is unnecessary for -20oC storage. |
Background Information
Human SerpinA3, also known as Alpha 1-antichymotrypsin (AACT), is a member of the serine protease inhibitor class, and is a plasma alpha globulin glycoprotein which increases in the blood during the inflammatory process. SerpinA3, is also an inhibitor of neutrophil cathepsin G, mast cell chymases and pancreatic chymotrypsin. SerpinA3 is produced primarily in the liver, and is identified as an acute-phase inflammatory protein. SerpinA3 deficiency has been associated with liver disease. SerpinA3 has also been implicated in the pathology of a number of devastating human diseases including chronic obstructive pulmonary disease (COPD), Parkinson's disease (PD), Alzheimer's disease (AD), Stroke, Cystic Fibrosis, Cerebral Haemorrhage and Multiple System Atrophy.
Protocols
| Product Specific Protocols | |
|---|---|
| FC protocol for Alpha 1 antichymotrypsin antibody 12192-1-AP | Download protocol |
| IHC protocol for Alpha 1 antichymotrypsin antibody 12192-1-AP | Download protocol |
| IP protocol for Alpha 1 antichymotrypsin antibody 12192-1-AP | Download protocol |
| WB protocol for Alpha 1 antichymotrypsin antibody 12192-1-AP | Download protocol |
| Standard Protocols | |
|---|---|
| Click here to view our Standard Protocols |
Publications
| Species | Application | Title |
|---|---|---|
Nat Metab Maternal exercise prevents metabolic disorders in offspring mice through SERPINA3C | ||
Acta Neuropathol Integrative proteomics highlight presynaptic alterations and c-Jun misactivation as convergent pathomechanisms in ALS | ||
Front Immunol Screening and identification of tissue-infiltrating immune cells and genes for patients with emphysema phenotype of COPD | ||
Br J Cancer Identification of GlcNAcylated alpha-1-antichymotrypsin as an early biomarker in human non-small-cell lung cancer by quantitative proteomic analysis with two lectins. | ||
Front Med (Lausanne) An Integrated Proteomics and Metabolomics Strategy for the Mechanism of Calcium Oxalate Crystal-Induced Kidney Injury. | ||